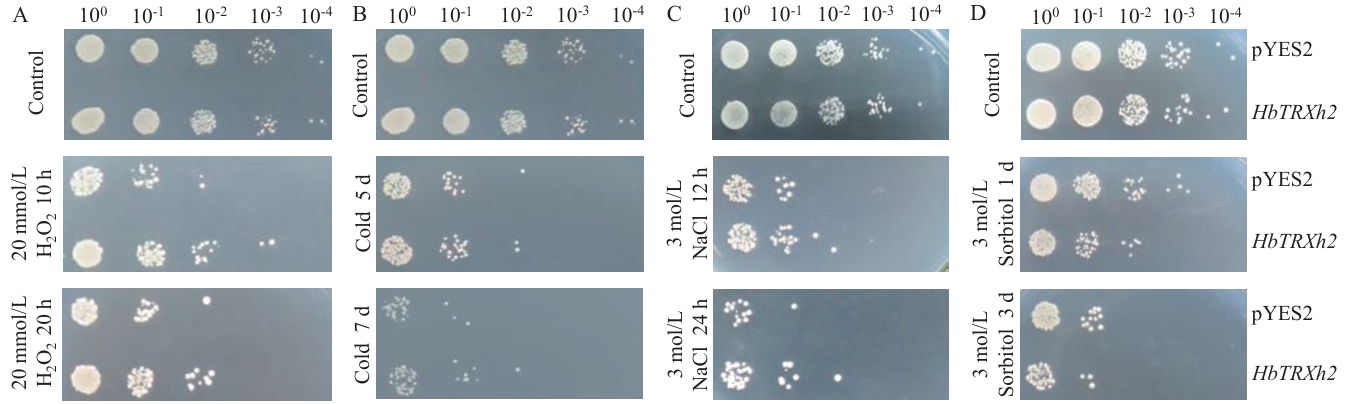

• 研究报告 • 下一篇
杨洁( ), 王玉婷, 冯成天, 何其光, 张明亮, 袁坤, 王真辉, 刘辉(
), 王玉婷, 冯成天, 何其光, 张明亮, 袁坤, 王真辉, 刘辉( )
)
收稿日期:2025-07-29
出版日期:2026-03-09
通讯作者:
刘辉,男,博士,研究员,研究方向 :植物生理与分子生物学;E-mail: liuhui@catas.cn作者简介:杨洁,女,硕士,研究实习员,研究方向 :植物生理与分子生物学;E-mail: yangjie8681@yeah.net
基金资助:
YANG Jie( ), WANG Yu-ting, FENG Cheng-tian, HE Qi-guang, ZHANG Ming-liang, YUAN Kun, WANG Zhen-hui, LIU Hui(
), WANG Yu-ting, FENG Cheng-tian, HE Qi-guang, ZHANG Ming-liang, YUAN Kun, WANG Zhen-hui, LIU Hui( )
)
Received:2025-07-29
Published:2026-03-09
摘要:
目的 探究橡胶树硫氧还蛋白(TRX)基因HbTRXh2的表达特性及其在低温胁迫中的功能,为橡胶树抗寒性遗传改良提供可用的基因资源。 方法 基于RT-PCR技术从橡胶树克隆HbTRXh2,运用生物信息学手段解析其序列特征及系统进化关系。采用实时荧光定量PCR(RT-qPCR)技术系统测定HbTRXh2在橡胶树不同组织中的表达水平以及各种非生物胁迫和激素处理后该基因的表达变化。此外,基于酵母表达系统,评估了HbTRXh2在应对低温、盐、干旱和氧化胁迫中的生物学功能。 结果 橡胶树HbTRXh2的开放阅读框(ORF)为405 bp,编码134个氨基酸。生物信息学预测显示,该蛋白理论等电点(pI)为5.78,分子量为14.64 kD。HbTRXh2含有TRX保守结构域,系统进化树分析显示其属于h型TRX。RT-qPCR分析显示,HbTRXh2在稳定期叶片中呈现最高表达量。非生物胁迫(低温、干旱、盐和氧化胁迫)以及植物激素(脱落酸、水杨酸、乙烯和茉莉酸)处理均显著上调了HbTRXh2表达。比较pYES2-HbTRXh2转化酵母和空载体pYES2转化(对照)酵母在低温、盐、干旱和氧化胁迫处理后的存活差异发现,与对照相比,转pYES2-HbTRXh2酵母在低温、盐和氧化胁迫处理后的存活率显著提高,而在山梨醇模拟干旱胁迫处理后的存活率显著降低。转HbTRXh2提高了酵母对低温、盐和氧化胁迫的抗性,但降低了对干旱胁迫的抗性。 结论 HbTRXh2参与橡胶树对非生物胁迫以及植物激素的应答,其在酵母中的异源表达显著增强了对低温、盐和氧化胁迫的抗性,但降低了抗旱性。
杨洁, 王玉婷, 冯成天, 何其光, 张明亮, 袁坤, 王真辉, 刘辉. 橡胶树HbTRXh2的克隆、表达及功能分析[J]. 生物技术通报, doi: 10.13560/j.cnki.biotech.bull.1985.2025-0895.
YANG Jie, WANG Yu-ting, FENG Cheng-tian, HE Qi-guang, ZHANG Ming-liang, YUAN Kun, WANG Zhen-hui, LIU Hui. Cloning, Expression Analysis, and Functional Characterization of the HbTRXh2 Gene from Hevea brasiliensis[J]. Biotechnology Bulletin, doi: 10.13560/j.cnki.biotech.bull.1985.2025-0895.
引物名称 Primer name | 引物序列 Primer sequence (5'‒3') | 用途 Purpose |
|---|---|---|
| HbTRXh2-GF | 酵母表达载体构建 | |
| HbTRXh2-GR | ||
| HbTRXh2-QF | ATTTTGCTGCATCGTGGTGT | RT-qPCR |
| HbTRXh2-QR | ACGTTGGCATAGCCTGAACT | |
| HbUBC4-QF | TTTCTTTGGTGACGCTGCAA | 橡胶树内参基因 |
| HbUBC4-QR | TCACCCTGAACCTGATAGCC | |
| pYES2-YF | TAATACGACTCACTATAGGG | pYES2载体检测 |
| pYES2-YR | ATTAAAGCCTTCGAGCGTCC | |
| Actin-F | AGTTGCCCCAGAAGAACACC | 酵母内参基因 |
| Actin-R | TACCGGCAGATTCCAAACCC |
表1 引物序列和用途
Table 1 Primer sequences and their applications
引物名称 Primer name | 引物序列 Primer sequence (5'‒3') | 用途 Purpose |
|---|---|---|
| HbTRXh2-GF | 酵母表达载体构建 | |
| HbTRXh2-GR | ||
| HbTRXh2-QF | ATTTTGCTGCATCGTGGTGT | RT-qPCR |
| HbTRXh2-QR | ACGTTGGCATAGCCTGAACT | |
| HbUBC4-QF | TTTCTTTGGTGACGCTGCAA | 橡胶树内参基因 |
| HbUBC4-QR | TCACCCTGAACCTGATAGCC | |
| pYES2-YF | TAATACGACTCACTATAGGG | pYES2载体检测 |
| pYES2-YR | ATTAAAGCCTTCGAGCGTCC | |
| Actin-F | AGTTGCCCCAGAAGAACACC | 酵母内参基因 |
| Actin-R | TACCGGCAGATTCCAAACCC |

图1 HbTRXh2编码区核苷酸序列及其编码的氨基酸序列黄色表示TRX结构域,下划线表示CGPC氧化还原活性中心
Fig. 1 Nucleotide sequences of the coding region of HbTRXh2 gene and its encoded amino acid sequenceThe TRX domain is highlighted in yellow background, and the CGPC redox-active center is underlined

图3 HbTRXh2在橡胶树不同组织中的表达模式不同小写字母表示组织之间存在显著差异(P<0.05)。下同
Fig. 3 Expression pattern of HbTRXh2 gene in different tissues of rubber treeDifferent lowercase letters denote significant differences between tissues (P<0.05). The same below

图6 HbTRXh2重组酵母的分子检测A:HbTRXh2重组酵母PCR验证;B:转化酵母中HbTRXh2的半定量PCR分析。M:DL2000 DNA marker(TaKaRa);N1、N2:未加模板的阴性对照;P1:pYES2质粒阳性对照;P2:pYES2-HbTRXh2质粒阳性对照;1‒3:pYES2转化酵母单克隆;4‒6:pYES2-HbTRXh2转化酵母单克隆
Fig. 6 Molecular verification of HbTRXh2 recombinant yeastA: PCR verification of HbTRXh2 recombinant yeast. B: Semi-quantitative PCR analysis of HbTRXh2 expression in transformed yeast. M: DL2000 DNA marker (TaKaRa); N1 and N2: Negative control without template; P1: pYES2 plasmid positive control; P2: pYES2-HbTRXh2 plasmid positive control; 1-3: pYES2 transformed yeast monoclonal; 4-6: pYES2-HbTRXh2 transformed yeast monoclonal
图7 转HbTRXh2酵母与转pYES2空载体对照酵母在氧化(A)、低温(B)、盐(C)和干旱(D)胁迫处理后的存活差异
Fig. 7 Survival differences between HbTRXh2 transgenic yeast and pYES2 empty vector-transformed yeast (Control) after oxidative (A), low temperature (B), salt (C), and drought (D) stress treatments
| [1] | Fukushi Y, Yokochi Y, Hisabori T, et al. Plastidial thioredoxin-like proteins are essential for normal embryogenesis and seed development in Arabidopsis thaliana [J]. J Plant Res, 2025, 138(2): 337-345. |
| [2] | Zhou JF, Song TQ, Zhou HW, et al. Genome-wide identification, characterization, evolution, and expression pattern analyses of the typical thioredoxin gene family in wheat (Triticum aestivum L.) [J]. Front Plant Sci, 2022, 13: 1020584. |
| [3] | Chibani K, Pucker B, Dietz KJ, et al. Genome-wide analysis and transcriptional regulation of the typical and atypical thioredoxins in Arabidopsis thaliana [J]. FEBS Lett, 2021, 595(21): 2715-2730. |
| [4] | Cui XY, Gu JM, Liu PK, et al. Genome-wide identification and characterization of the thioredoxin (TRX) gene family in tomato (Solanum lycopersicum) and a functional analysis of SlTRX2 under salt stress [J]. Plant Physiol Biochem, 2025, 220: 109478. |
| [5] | Geigenberger P, Thormählen I, Daloso DM, et al. The unprecedented versatility of the plant thioredoxin system [J]. Trends Plant Sci, 2017, 22(3): 249-262. |
| [6] | Ji MG, Park HJ, Cha JY, et al. Expression of Arabidopsis thaliana Thioredoxin-h2 in Brassica napus enhances antioxidant defenses and improves salt tolerance [J]. Plant Physiol Biochem, 2020, 147: 313-321. |
| [7] | Ji H, Liu D, Zhang Z, et al. A bacterial F-box effector suppresses SAR immunity through mediating the proteasomal degradation of OsTrxh2 in rice [J]. Plant J, 2020, 104(4): 1054-1072. |
| [8] | Meng L, Wong JH, Feldman LJ, et al. A membrane-associated thioredoxin required for plant growth moves from cell to cell, suggestive of a role in intercellular communication [J]. Proc Natl Acad Sci, 2010, 107(8): 3900-3905. |
| [9] | Chae HB, Jung YJ, Paeng SK, et al. Functional changes of OsTrxm from reductase to molecular chaperone under heat shock stress [J]. Plant Physiol Biochem, 2023, 203: 108005. |
| [10] | Digiuni S, Schellmann S, Geier F, et al. A competitive complex formation mechanism underlies trichome patterning on Arabidopsis leaves [J]. Mol Syst Biol, 2008, 4(1): 217. |
| [11] | Park SK, Jung YJ, Lee JR, et al. Heat-shock and redox-dependent functional switching of an h-type Arabidopsis thioredoxin from a disulfide reductase to a molecular chaperone [J]. Plant Physiol, 2009, 150(2): 552-561. |
| [12] | Tian Y, Fan M, Qin Z, et al. Hydrogen peroxide positively regulates brassinosteroid signaling through oxidation of the BRASSINAZOLE-RESISTANT1 transcription factor [J]. Nat Commun, 2018, 9(1): 1063. |
| [13] | Kamoun H, Feki K, Tounsi S, et al. The thioredoxin h-type TdTrxh2 protein of durum wheat confers abiotic stress tolerance of the transformant Arabidopsis plants through its protective role and the regulation of redox homoeostasis [J]. Protoplasma, 2024, 261(2): 317-331. |
| [14] | Cejudo FJ, González MC, Pérez-Ruiz JM. Redox regulation of chloroplast metabolism [J]. Plant Physiol, 2021, 186(1): 9-21. |
| [15] | De Brasi-Velasco S, Sánchez-Guerrero A, Castillo MC, et al. Thioredoxin TRXo1 is involved in ABA perception via PYR1 redox regulation [J]. Redox Biol, 2023, 63: 102750. |
| [16] | Matsuzawa A. Thioredoxin and redox signaling: Roles of the thioredoxin system in control of cell fate [J]. Arch Biochem Biophys, 2017, 617: 101-105. |
| [17] | 卫晋瑶, 郑红裕, 石钰欣. 2024年我国天然橡胶产业形势分析及未来展望 [J]. 中国热带农业, 2025(2): 17-22, 7. |
| Wei JY, Zheng HY, Shi YX. Analysis of China’s natural rubber industry in 2024 and future outlook [J]. China Trop Agric, 2025(2): 17-22, 7. | |
| [18] | 刘琰琰, 韩冬, 杨菲, 等. 气象灾害对橡胶树的影响及风险评估综述 [J]. 福建林业科技, 2016, 43(3): 244-252. |
| Liu YY, Han D, Yang F, et al. Studies for impact of meteorological disasters on Hevea brasiliensis and risk assessment [J]. J Fujian For Sci Technol, 2016, 43(3): 244-252. | |
| [19] | 孙永帅, 田维敏, 翟德利, 等. 我国橡胶树育种的技术瓶颈与创新发展建议 [J]. 中国科学院院刊, 2024, 39(1): 191-197. |
| Sun YS, Tian WM, Zhai DL, et al. Technological bottlenecks and innovative developments for rubber tree breeding in China [J]. Bull Chin Acad Sci, 2024, 39(1): 191-197. | |
| [20] | 吴双, 逯锐琳, 冯成天, 等. 橡胶树HbTRXh5基因在酵母中的表达及抗逆性分析 [J]. 生物技术通报, 2024, 40(12): 136-144. |
| Wu S, Lu RL, Feng CT, et al. Expression of HbTRXh5 gene of Hevea brasiliensis in yeast and analysis on its resistance to stress [J]. Biotechnol Bull, 2024, 40(12): 136-144. | |
| [21] | 王帅, 袁坤, 何其光, 等. 橡胶树硫氧还蛋白基因HbCXXS1的克隆及表达分析 [J]. 生物技术通报, 2022, 38(12): 214-222. |
| Wang S, Yuan K, He QG, et al. Cloning and expression analysis of HbCXXS1, a thioredoxin gene in Hevea brasiliensis [J]. Biotechnol Bull, 2022, 38(12): 214-222. | |
| [22] | 李双江, 冯成天, 胡义钰, 等. 橡胶树HbDHAR2基因克隆及表达分析 [J]. 华北农学报, 2021, 36(3): 25-32. |
| Li SJ, Feng CT, Hu YY, et al. Cloning and expression analysis of HbDHAR2 gene from Hevea brasiliensis [J]. Acta Agric Boreali Sin, 2021, 36(3): 25-32. | |
| [23] | Schmittgen TD, Livak KJ. Analyzing real-time PCR data by the comparative Ct method [J]. Nat Protoc, 2008, 3(6): 1101-1108. |
| [24] | Nascimento CP, da Fonseca-Pereira P, Ferreira-Silva M, et al. Functional analysis of the extraplastidial TRX system in germination and early stages of development of Arabidopsis thaliana [J]. Plant Sci, 2025, 350: 112310. |
| [25] | Reichheld JP, Mestres-Ortega D, Laloi C, et al. The multigenic family of thioredoxin h in Arabidopsis thaliana: specific expression and stress response [J]. Plant Physiol Biochem, 2002, 40(6-8): 685-690. |
| [26] | Timm S, Klaas N, Niemann J, et al. Thioredoxins o1 and h2 jointly adjust mitochondrial dihydrolipoamide dehydrogenase-dependent pathways towards changing environments [J]. Plant Cell Environ, 2024, 47(7): 2540-2558. |
| [27] | Jiang CL, Dai JX, Han HL, et al. Determination of thirteen acidic phytohormones and their analogues in tea (Camellia sinensis) leaves using ultra high performance liquid chromatography tandem mass spectrometry [J]. J Chromatogr B, 2020, 1149: 122144. |
| [28] | Kavi Kishor PB, Tiozon RN Jr, Fernie AR, et al. Abscisic acid and its role in the modulation of plant growth, development, and yield stability [J]. Trends Plant Sci, 2022, 27(12): 1283-1295. |
| [29] | Verma V, Ravindran P, Kumar PP. Plant hormone-mediated regulation of stress responses [J]. BMC Plant Biol, 2016, 16(1): 86. |
| [30] | Ben Saad R, Ben Romdhane W, Bouteraa MT, et al. Lobularia maritima thioredoxin-h2 gene mitigates salt and osmotic stress damage in tobacco by modeling plant antioxidant system [J]. Plant Growth Regul, 2022, 97(1): 101-115. |
| [31] | Lee ES, Park JH, Wi SD, et al. Redox-dependent structural switch and CBF activation confer freezing tolerance in plants [J]. Nat Plants, 2021, 7(7): 914-922. |
| [32] | Xu A, Wei N, Hu H, et al. Thioredoxin h2 inhibits the MPKK5-MPK3 cascade to regulate the CBF-COR signaling pathway in Citrullus lanatus suffering chilling stress [J]. Hortic Res, 2023, 10(2): uhac256. |
| [1] | 殷亚龙, 张明洋, 王洁敏, 苗雪雪, 陈劲, 王伟平. 水稻非生物胁迫协同耐受机制研究进展[J]. 生物技术通报, 2026, 42(4): 26-37. |
| [2] | 陈登科, 兰刚, 夏芝, 侯保国, 杨六六, 曹彩荣, 李朋波, 吴翠翠. 花生ZF-HD基因家族的鉴定和非生物胁迫响应分析[J]. 生物技术通报, 2026, 42(4): 114-128. |
| [3] | 程婷婷, 刘俊, 王利丽, 练从龙, 魏文君, 郭辉, 吴尧琳, 杨晶凡, 兰金旭, 陈随清. 杜仲查尔酮异构酶基因家族全基因组鉴定及其表达模式分析[J]. 生物技术通报, 2025, 41(9): 242-255. |
| [4] | 程雪, 付颖, 柴晓娇, 王红艳, 邓欣. 谷子LHC基因家族鉴定及非生物胁迫表达分析[J]. 生物技术通报, 2025, 41(8): 102-114. |
| [5] | 张学琼, 潘素君, 李魏, 戴良英. 植物磷酸盐转运蛋白在胁迫响应中的研究进展[J]. 生物技术通报, 2025, 41(7): 28-36. |
| [6] | 韩燚, 侯昌林, 唐露, 孙璐, 谢晓东, 梁晨, 陈小强. 大麦HvERECTA基因的克隆及功能分析[J]. 生物技术通报, 2025, 41(7): 106-116. |
| [7] | 李霞, 张泽伟, 刘泽军, 王楠, 郭江波, 辛翠花, 张彤, 简磊. 马铃薯转录因子StMYB96的克隆及功能研究[J]. 生物技术通报, 2025, 41(7): 181-192. |
| [8] | 龚钰涵, 陈兰, 尚方慧子, 郝灵颖, 刘硕谦. 茶树TRB基因家族鉴定及表达模式分析[J]. 生物技术通报, 2025, 41(7): 214-225. |
| [9] | 魏雨佳, 李岩, 康语涵, 弓晓楠, 杜敏, 涂岚, 石鹏, 于子涵, 孙彦, 张昆. 白颖苔草CrMYB4基因的克隆和表达分析[J]. 生物技术通报, 2025, 41(7): 248-260. |
| [10] | 吴浩, 董伟峰, 贺子天, 李艳肖, 谢辉, 孙明哲, 沈阳, 孙晓丽. 水稻BXL基因家族的全基因组鉴定及表达分析[J]. 生物技术通报, 2025, 41(6): 87-98. |
| [11] | 黄丹, 彭兵阳, 张盼盼, 焦悦, 吕佳斌. 油茶HD-Zip基因家族鉴定及其在非生物胁迫下的表达分析[J]. 生物技术通报, 2025, 41(6): 191-207. |
| [12] | 彭绍智, 王登科, 张祥, 戴雄泽, 徐昊, 邹学校. 辣椒CaFD1基因克隆、表达特征及功能验证[J]. 生物技术通报, 2025, 41(5): 153-164. |
| [13] | 刘源, 赵冉, 卢振芳, 李瑞丽. 植物类胡萝卜素生物代谢途径及其功能研究进展[J]. 生物技术通报, 2025, 41(5): 23-31. |
| [14] | 张益瑄, 马宇, 王童童, 盛苏奥, 宋家凤, 吕钊彦, 朱晓彪, 侯华兰. 马铃薯DIR家族全基因组鉴定及表达模式分析[J]. 生物技术通报, 2025, 41(3): 123-136. |
| [15] | 韩江涛, 张帅博, 秦雅蕊, 韩硕洋, 张雅康, 王吉庆, 杜清洁, 肖怀娟, 李猛. 甜瓜β-淀粉酶基因家族的鉴定及对非生物胁迫的响应[J]. 生物技术通报, 2025, 41(3): 171-180. |
| 阅读次数 | ||||||
|
全文 |
|
|||||
|
摘要 |
|
|||||